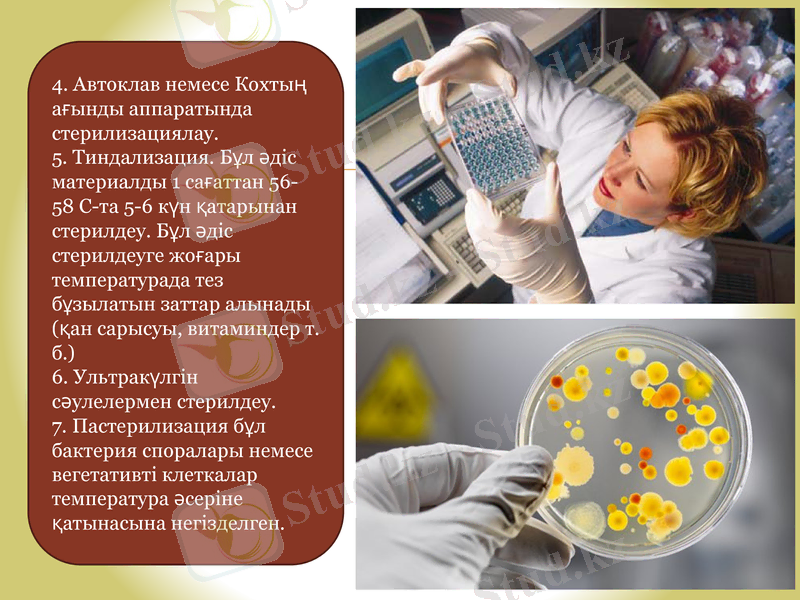
Slide 9

Биопрепараттар технологиясында стерильді ыдыстарды дайындаудың әдістері мен тәсілдері



Биопрепараттар
технологиясында
стерильды ыдысты
дайындау әдістері
мен тәсілдері

Биотехнология-биологиялық процестер мен белгілі бір қасиеттері бар, тиімділігі жоғары микроорганизмдердің формаларын, өсімдік пен жануарлардың ұлпаларын клетка өсінділерін өндірісте қолдану.
Биопрепараттар - жұқпалы ауруларды анықтау, олардың алдын алу, емдеу және балау мақсатында қолданылатын препараттар. Олар емдік, алдын алу және балау мақсатында қолданылатын препараттар.
Стерилизация - микроорганизмдердің вегетативті формаларын және олардың споралы материалдарын толығымен жою.
Пастерилизация - бұл бактерия споралары немесе вегетативті клеткалар температура әсеріне қатынасына негізделген.
Механикалық стерилизация (фильтрлеу) - бұл әдіс микроорганизмдерді және олардың спораларын ұсақ поралы фильтрмен механикалық ұстап қалу қасиетіне негізделген.
Химиялық стерилизация - бұл әдісте әртүрлі бактерициттік қасиеті бар химиялық заттар қолданылады.
АНЫҚТАМАЛАР

ҚР - Қазақстан Республикасы
ҚР АШМ - Қазақстан Республикасының ауыл шаруашылық министрлігі
мкг - микрограмм
мл - миллилитр
ГАТ - гипоксантин-аминоптерин-тимидин
кД - килодальтон
ОФД - ортофенилендиамин
ФТЕ - фосфатты тұз ерітіндісі
pH - ерітіндінің қышқылдығы
Н - ерітіндінің нормасы
М - ерітіндінің молярлығы
ҚЫСҚАРТУЛАР

Соңғы жылдары басқарумен өткізілетін биологиялық технологияларды пайдалану арқылы маңызды өнімдер алынуда. Бұл технологиялардың негізінде әртүрлі биологиялық агенттердің каталитикалық потенциалдары мен биологиялық жүйелер пайдалануда, атап айтқанда - микроорганизмдер, вирустар, өсімдіктер мен жануарлар жасушалары мен ұлпалары, сонымен қатар жасушадан тыс орналасқан заттар мен жасушалық компоненттер. Қазіргі кезеңде көптеген дамыған елдердің ғалымдары жаңа биотехнологиялық әдістерді шығаруда және оларды нәтижелі игеруде, өнімдерін сапасын жақсартуда, жемісті еңбектенуде.
Ауыл шаруашылық биотехнологиясында, фармацевтикалық, тағам және химия өндірістерде, амин қышқылдарын, ақуыздарды, ферменттерді, медикаменттерді препараттарын синтездеуде көптеген тәжірибелік мәліметтер жинақталынды.

Қазақстан Республикасы биотехнологияның түрлі саласында жаңа техникалар мен технологияларды игерген, фундаментальды және қолданбалы зерттеулерді белсенді жүргізетін, алдыңғы қатарлы дамыған елдердің қатарына кіреді. Ген инженериясының жаңа технологиялары дәстүрлі биотехнологиялық процестердің деңгейлерін жоғарлатуға және бұрын қол жеткізбейтін бағалы өнімдерді алуға жол ашады.
Қазіргі заман талаптарына сәйкес биотехнологиялық өндірістері қалыптастыру, Қазақстандық биоөнімдерді әлемдік экономикалық кеңістікте бәсекелестіруге және экспортқа шығарудың негізгі жолы болып отыр.

Химиялық реактивтер, химиялық реагенттер - лабораторияларда анализ жасауда, ғылыми-зерттеу жұмыстарында түрлі қосылыстардың химиялық өзгерісін, қасиеттерін, алыну әдістерін анықтау, т. б. мақсаттар үшін қолданылатын химиялық препараттар. Химиялық реактивтер көбіне жеке заттар болғанымен кейбір заттардың қоспасы да (мысалы, петролейн эфирі) реактивтерге жатады.
Тазалығына қарай Химиялық реактивтер ерекше тазартылған, химиялық таза, анализ үшін таза, аса тазартылған, техникалық өнім деп бөлінеді. Реактивтердің тазалығы Мемлекеттік Стандарттың 9. 6. 6 бабына сәйкес болуы керек. Химиялық реактивтердің аты жазылған қағазда атауы, формуласы, қоспасының мөлшері көрсетіледі.

Химиялық реактивтер құрамына қарай анорганикалық, органикалық, құрамында радиоактивті изотоптары бар реактивтер, ал қолданылуына қарай аналитикалық реактивтер, сондай-ақ химиялық индикаторлар, органикалық еріткіштер болып бөлінеді. Органикалық функционалды анализ үшін қолданылатын Химиялық реактивтер белгілі, мысалы, 2, 4-динитрофенилгидразин, фенилгидразин, семикарбазид альдегидтер мен кетондардың саны мен сапасын анықтауда қолданылады. Улы, тез тұтанатын, қопарылуы қауіпті Химиялық реактивтерде бар, сондықтан оларды қолданғанда белгілі ережелерді бұзбау керек. Ауа әсерінен оңай бұзылатын реактивтерді жабық шыны ыдыстарда сақтайды. [1] .

Стерилизация- микроорганизмдердің вегетативті формаларын және олардың споралы материалдарын толығымен жою.
Ыдыстарды (С. 1) стерилизациялаудың физикалық әдістеріне мыналар жатады:
1. Газды жаңғышпен немесе спирт жалынымен қыздыру. Берілген әдіс шектеулі түрде қолданылады. Мысалы׃ бактериологиялық ілмекті, ине, пинцеттерді стерилдеуде.
2. Құрғақ ыстық кептіру шкафында стерилизациялау ( Пастер әдісі) . Бұл әдіс 45 минут ішінде 165-170 С қыздырылған ауада бактерициттікке негізделген. Өте жоғары температурада ыдысты қағаз ораған дәкелі тығын күйіп кетеді, ал төменгі температурадағы стерилизация бірнеше мерзімді қажет етеді. Петри шынысы, пробирка, пипетка, ыстық шыны ыдыстарды стерилизациялайды.
3. Буды қысыммен булау стерилизаторында стерилдеу (Автоклав) .
4. Автоклав немесе Кохтың ағынды аппаратында стерилизациялау.
5. Тиндализация. Бұл әдіс материалды 1 сағаттан 56-58 С-та 5-6 күн қатарынан стерилдеу. Бұл әдіс стерилдеуге жоғары температурада тез бұзылатын заттар алынады (қан сарысуы, витаминдер т. б. )
6. Ультракүлгін сәулелермен стерилдеу.
7. Пастерилизация бұл бактерия споралары немесе вегетативті клеткалар температура әсеріне қатынасына негізделген.

- Іс жүргізу
- Автоматтандыру, Техника
- Алғашқы әскери дайындық
- Астрономия
- Ауыл шаруашылығы
- Банк ісі
- Бизнесті бағалау
- Биология
- Бухгалтерлік іс
- Валеология
- Ветеринария
- География
- Геология, Геофизика, Геодезия
- Дін
- Ет, сүт, шарап өнімдері
- Жалпы тарих
- Жер кадастрі, Жылжымайтын мүлік
- Журналистика
- Информатика
- Кеден ісі
- Маркетинг
- Математика, Геометрия
- Медицина
- Мемлекеттік басқару
- Менеджмент
- Мұнай, Газ
- Мұрағат ісі
- Мәдениеттану
- ОБЖ (Основы безопасности жизнедеятельности)
- Педагогика
- Полиграфия
- Психология
- Салық
- Саясаттану
- Сақтандыру
- Сертификаттау, стандарттау
- Социология, Демография
- Спорт
- Статистика
- Тілтану, Филология
- Тарихи тұлғалар
- Тау-кен ісі
- Транспорт
- Туризм
- Физика
- Философия
- Халықаралық қатынастар
- Химия
- Экология, Қоршаған ортаны қорғау
- Экономика
- Экономикалық география
- Электротехника
- Қазақстан тарихы
- Қаржы
- Құрылыс
- Құқық, Криминалистика
- Әдебиет
- Өнер, музыка
- Өнеркәсіп, Өндіріс
Қазақ тілінде жазылған рефераттар, курстық жұмыстар, дипломдық жұмыстар бойынша біздің қор #1 болып табылады.



Ақпарат
Қосымша
Email: info@stud.kz